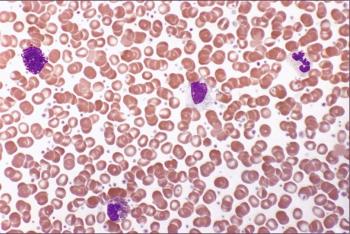

This series examines how recent prostate cancer guidelines translate into practice, covering the expansion of radiopharmaceuticals and PARP inhibitors into earlier disease settings, the reorganization of mCRPC therapy by prior treatment exposure, updated patient selection criteria for radium-223, the indispensable role of PSMA PET imaging, and the sequencing questions that remain.